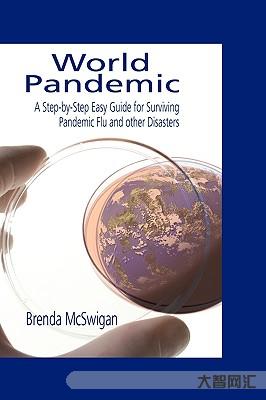

pandemic这是什么意思?
pandemic它是一个英语单词,可以用作形容词和名词。形容词的意思是(疾病)在全国(或世界)流行。
近义词:widespread,universal,ruling,generalizedinfluenzapandemic流感很受欢迎;流感警告
PandemicBoy传播病毒男孩;传播病毒病毒;
trigginganinfluenzapandemic引起流感流行;刺激流感流行;引起流感流行
PandemicInfluenza大流行流感;大流感;大流行;大流行流感
pandemicdisease大列病;大流行病
Pandemicinfection世界性传染
flupandemic流感大流行
theAIDSpandemic艾滋病很受欢迎
西班牙流感的爆发夺走了近2万人的生命。
柯林斯例句
2.Theyfearedanewcholerapandemic.
他们担心新一轮霍乱的流行。
柯林斯例句
3.Insomepartsoftheworldmalariaisstillpandemic.
疟疾在世界某些地区仍具有高传染性。
来自辞典例句
4.Soconceivably,thisthingcouldbeusedtocreateapandemic.
因此,可以想象这种仪器可以用来引起大瘟疫.





















